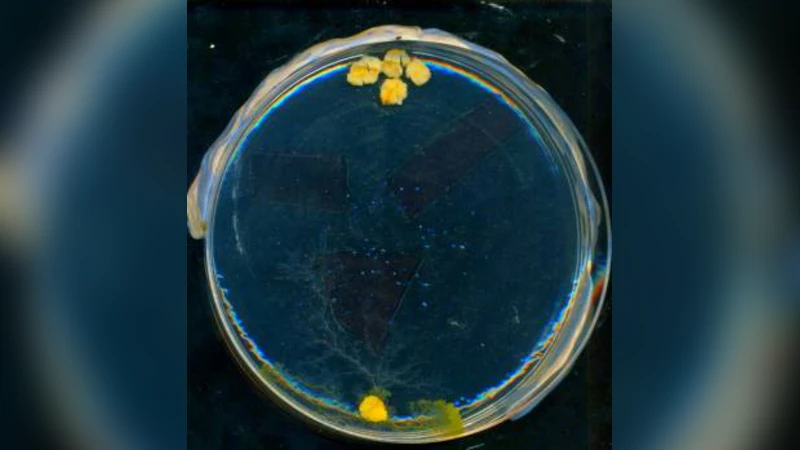
빛으로 조종하는 물곰팡이 컴퓨팅

빛으로 조종하는 물곰팡이 컴퓨팅
초록
이 논문은 광원에 대한 물곰팡이(Physarum polycephalum)의 움직임을 실험적으로 분석하고, 빛에 의해 유도된 플라스미드의 이동을 흥분성 매질의 파동 조각과 유사하게 모델링한다. 평면 광 영역을 설계함으로써 플라스미드 기반 연산 장치를 정밀하게 제어하고, 분산 센싱·병렬 처리·분산 최적화 능력을 활용한 새로운 바이오‑컴퓨팅 패러다임을 제시한다.
상세 분석
본 연구는 물곰팡이 플라스미드가 빛에 민감한 광회피성(photophobic) 특성을 이용해 동적 프로그래밍이 가능한 ‘Physarum 머신’으로서의 가능성을 탐구한다. 실험에서는 균사체를 영양이 풍부한 겔 위에 배치하고, 레이저 혹은 LED를 이용해 국소적인 광점(illumination spot)과 광선(illumination stripe)을 생성하였다. 플라스미드는 빛이 조사된 영역을 회피하면서 성장 방향을 바꾸고, 이는 마치 흥분성 매질에서 발생하는 파동 조각(traveling wave‑fragment)이 회피성 경계에 부딪혀 굴절·반사되는 현상과 유사하게 나타난다. 저자들은 이러한 현상을 수학적으로 FitzHugh‑Nagumo 모델의 파라미터를 변형한 반응‑확산 방정식으로 근사화하고, 실험 데이터와 시뮬레이션 결과를 정량적으로 비교하였다.
핵심적인 기술적 통찰은 다음과 같다. 첫째, 빛의 강도와 파장, 조사 면적을 정밀하게 조절함으로써 플라스미드의 이동 속도와 방향을 미세하게 제어할 수 있다. 강도가 높을수록 회피 반응이 급격히 일어나며, 얕은 광 영역은 플라스미드가 일시적으로 멈추거나 우회하도록 만든다. 둘째, 복합적인 광 패턴—예를 들어 교차하는 광선이나 회전하는 광 원—을 이용하면 플라스미드가 복잡한 경로를 따라 이동하도록 ‘프로그래밍’할 수 있다. 이는 기존의 물리적 장벽이나 화학적 격자와 달리 비접촉식으로 재구성이 가능하다는 장점을 제공한다. 셋째, 플라스미드가 형성하는 네트워크 구조는 빛에 의해 동적으로 재배치될 수 있다. 저자들은 빛에 의해 유도된 ‘절단’과 ‘재연결’ 과정을 관찰했으며, 이는 분산 최적화 문제(예: 최단 경로 탐색, 최소 스패닝 트리 구성) 해결에 활용될 수 있다.
또한, 플라스미드와 흥분성 매질 사이의 유사성은 두 시스템 모두 비선형 반응‑확산 메커니즘에 기반한다는 점에서 의미가 깊다. 물곰팡이는 세포질 흐름과 사이토플라즘의 압력 차에 의해 이동하지만, 광회피 신호는 세포막의 전위 변화를 유도해 내부 신호 전달망을 활성화한다. 이러한 생물학적 신호는 수학적 모델에서 ‘억제 변수(inhibitor)’에 해당하며, 파동 조각이 회피성 경계에 부딪혔을 때 발생하는 ‘소멸(dissipation)’ 현상과 정량적으로 일치한다.
연구의 한계로는 광 회피 반응이 온도·습도·영양 상태에 따라 변동성이 크다는 점, 그리고 장시간 실험에서 플라스미드의 생존율이 감소한다는 점을 들 수 있다. 또한, 현재 제시된 광 패턴은 2차원 평면에 국한되며, 3차원 구조에서의 제어 메커니즘은 아직 미비하다. 향후 연구에서는 광유도 신호와 전기·화학 자극을 복합적으로 적용해 다중 입력·다중 출력 형태의 복합 연산을 구현하고, 마이크로플루이딕 채널과 결합해 실시간 피드백 제어 루프를 구축하는 방향이 제시된다.
댓글 및 학술 토론
Loading comments...
의견 남기기